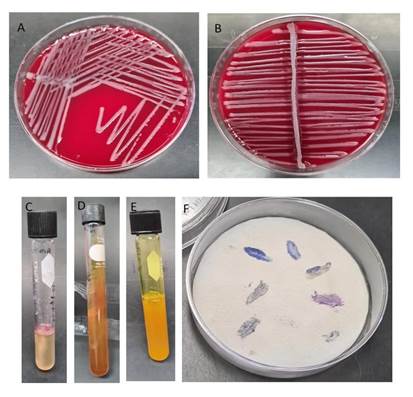

INTRODUCCIÓN
Pasteurella multocida es una bacteria Gram negativa que afecta a una amplia gama de especies domésticas. Es un patógeno que forma parte de la microbiota normal de cavidad oral, orofaringe y tracto respiratorio superior, actúa como agente primario y oportunista (Aktories et al., 2012; Register & Brockmeier, 2019). En los lepóridos causa bronconeumonía aguda y crónica, rinitis atrófica purulenta, sinusitis, atrofia de los cornetes nasales, distorsión del maxilar, también está asociada con otitis media, infección genital, pioderma, septicemia y afecta en su crecimiento (Massacci et al., 2018; D’Amico et al., 2022).
La pasteurelosis es una de las enfermedades bacterianas más graves del conejo provocando daños económicos en los sistemas de producción a nivel mundial (El Sheikh et al., 2021). Esta enfermedad suele ser endémica en la producción cunícola y su prevalencia se ha estimado entre el 7% y casi el 100% (Zhu et al., 2020). La aparición de enfermedades es inevitable en cualquier unidad de producción animal y conduce a pérdidas económicas (Quesada et al., 2013). Los conejos pueden infectarse con P. multocida después de su nacimiento y la incidencia de la infección aumenta con la edad hasta aproximadamente los 5 meses, con ello, la mayoría de los conejos adultos han sido infectados y son portadores de P. multocida (Palócz et al., 2014).
La transmisión antropozoonótica se produce a través de mordeduras de animales, arañazos, lamidos en abrasiones de la piel o por contacto con secreciones nasales, sin olvidar que P. multocida es el aislado más frecuente observado en las infecciones humanas (Souza, 2009; Wilson & Ho, 2013; Abreu et al., 2018; D’Amico et al., 2022). La prevalencia de antisueros frente a P. multocida fue 2 veces mayor en individuos sanos con exposición ocupacional (Wilson & Ho, 2013), lo que indica que la exposición a animales aumenta la probabilidad de infección y en casi todos los casos la muerte parece ser el resultado de una complicación de la infección adquirida a través del contacto con animales (Hey et al., 2012). La utilización de conejos como animales de compañía expone a los dueños a la infección por P. multocida; lo anterior ha sido documentado pero la problemática no ha sido determinada como un problema de salud pública (Lin et al., 2006; Per et al., 2010; Ferreira et al., 2016; D’Amico et al., 2022).
El sistema complemento está constituido por más de 50 proteínas circulantes que se producen en el hígado, la biosíntesis extrahepática ocurre en fibroblastos, células T y B, adipocitos y células endoteliales. El complemento genera una reacción enzimática en cadena que puede ser activado por tres vías: la vía clásica, la vía alterna y la vía de las lectinas (Bajic et al., 2015; Mathern & Heeger, 2015), participa en la respuesta inmune y se activa por el reconocimiento de patrones moleculares asociados con patógenos, células dañadas y complejos inmunes (Bajic et al., 2015). Para eliminar dichos patógenos, la cascada de complemento provoca su opsonización que facilita su fagocitosis, su lisis por la polimerización del complejo de ataque de membrana, así como una respuesta proinflamatoria que conduce al reclutamiento y la activación de células inmunitarias tanto de la respuesta inmune innata, como de la respuesta inmune adaptativa (Ricklin et al., 2010; Bajic et al., 2015; Mathern & Heeger, 2015).
La tendencia actual para el tratamiento de la pasteurelosis está basada en la aplicación de antibióticos, pero en los últimos años aumentó el interés por tener terapias alternativas para su tratamiento (Kubatzky, 2012; Moreno-Torres et al., 2019). El efecto del sistema complemento y su modulación para controlar el desarrollo de diversos microorganismos infecciosos han sido demostrados, pero la actividad del complemento sérico contra P. multocida aislada de conejo no ha sido evaluada. Por lo tanto, el presente estudio tiene como objetivo evaluar la actividad del complemento sérico humano sobre la capacidad de supervivencia de un aislado virulento de P. multocida tipo A.
MATERIAL Y MÉTODOS
Una coneja raza cabeza de león (Oryctolagus cuniculus) de seis meses que presentaba semiología compatible con neumonía productiva, con moderada secreción blanquecina de las fosas nasales, fue tratada con enrofloxacina vía oral por más de tres meses. Se realizó un hisopado de la secreción para el aislamiento del agente causal en agar sangre (AS) incubando por 24 h a 37ºC. Después de realizar el aislamiento en cultivo puro, se realizó la caracterización mediante técnicas de identificación fenotípica estándar y para la identificación del tipo capsular se hizo la prueba de hialuronidasa y acriflavina siguiendo las metodologías descritas por Koneman & Allen (2008). Los procedimientos contenidos en el presente trabajo fueron avalados por el Comité interno para el cuidado y uso de los animales (CICUA) oficio DC-2016/2-1.
Para los ensayos de supervivencia, la bacteria se subcultivó en agar sangre (AS) por 24 h, posteriormente una colonia fue inoculada en caldo infusión cerebro corazón (CICC) durante 16 h a 37 °C con agitación de 185 rpm hasta que el cultivo alcanzó una densidad óptica de 0.43 a 600 nm (aproximadamente 3.42 × 108 bacterias/mL). Posteriormente fue centrifugado a 4,400 Xg a 21 °C por 15 min, el sedimento bacteriano se lavó una vez con solución salina de fosfatos (PBS) y se ajustó a 1x103 bacterias/tubo. Se utilizó suero humano normal (SN) con complemento activo y para el control el complemento fue inactivado calentando el suero humano a 56 ºC por 30 min (SIC), la concentración final del suero fue del 40%. Las bacterias fueron incubadas con SN o con SIC a 37ºC por 30 min bajo agitación de 190 rpm. Después el cultivo se centrifugó a 5,500 Xg decantando el sobrenadante, la pastilla fue suspendida en 100 µL de PBS, se realizaron diluciones decuples hasta 10-4, para sembrar por extensión en AS por triplicado incubando a 37 °C por 18 h para determinar el número de unidades formadoras de colonias (UFC), se calculó el porcentaje de supervivencia considerando el número de colonias obtenidas tras la incubación con SIC como el 100% de supervivencia.
Los resultados de la prueba de supervivencia fueron analizados utilizando media, rango y desviación estándar, también se compararon mediante la prueba ANOVA de una vía donde un valor P < 0.05 se interpretó como significativo. Lo anterior fue realizado usando el programa GraphPad Prism versión 6.0.0 para Windows (GraphPad Prism, 2012).
RESULTADOS
Se aisló la bacteria en cultivo puro y de forma abundante en AS a partir del hisopado nasal de la coneja cabeza de león (Oryctolagus cuniculus) desarrollándose dentro de las 24 h de incubación. Después se realizó la tinción de Gram, se observaron bacilos Gram negativos y con la tinción de Giemsa bacilos con aspecto bipolar. Las pruebas bioquímicas realizadas se describen en la Tabla 1 y las imágenes en la Figura 1. La identificación del agente causal fue P. multocida y por la prueba de hialuronidasa fue subclasificado en el tipo capsular A.
Tabla 1 Pruebas bioquímicas estándar y antibiograma aplicadas al aislado de P.multocida obtenida de la coneja enferma.
| PRUEBA DE IDENTIFICACIÓN | Resultado | IDENTIFICACIÓN DE SEROTIPO | Resultado |
|---|---|---|---|
| Oxidasa | + | ||
| Agar TSI | 6 | Acriflavina | - |
| Motilidad | - | Hialuronidasa | + |
| Glucosa | + | ||
| Desarrollo en agar sangre | + | ANTIBIOGRAMA | |
| Hemólisis | - | Cefotaxima | S |
| Desarrollo en MacConkey | - | Ciprofloxacino | S |
| Reducción de Nitratos | + | Neomicina | R |
| Indol | + | Norfloxacina | S |
| Urea | - | Sulfametoxazol-trimetoprima | S |
| Citrato de Simmons | - | Imipenem | S |
Positivo (+), Negativo (-), Sensible (S), Resistente (R).
Figura 1 Pruebas bioquímicas aplicadas para la identificación de P. multocida aislada del hisopado nasal de la coneja cabeza de león. A) Cultivo puro en placa con agar sangre sin hemólisis. B) Prueba de hialuronidasa positiva. C) Prueba de SIM; indol positivo, producción de ácido sulfhídrico negativo y motilidad negativa. D) Prueba TSI; producción de gas negativo, producción de ácido sulfhídrico negativo y fondo y superficie amarillos. E) Prueba de acriflavina negativa. F) Prueba de oxidasa positiva.
El efecto del sistema complemento en P. multocida fue evaluado tras la incubación del cultivo bacteriano con SN o con SIC al 40 % durante 30 min. En diez experimentos independientes las bacterias viables fueron cuantificadas, el porcentaje de células supervivientes fue calculado comparando el número de bacterias viables incubadas en los dos tratamientos. Los resultados indican que el sistema complemento sérico tiene acción bactericida sobre P. multocida; el ensayo mostró que el cultivo tratado con el SN permitió la supervivencia in vitro del 51.07 ± 1.70 %, con respecto al SIC (P<0.05) (Figura 2).

Figura 2 supervivencia de P. multocida a la acción del sistema complemento presente en el suero. A la izquierda se muestra la cantidad de UFCs de P. multocida que desarrollaron después de incubarlas con SIC y a la derecha al incubarse con SN. SIC= suero Inactivado a 56 ºC durante 30 min. SN= suero normal (n=10). a-b Medias con distinta letra son estadísticamente diferentes (P<0.05).
DISCUSIÓN
Se confirmó la presencia de P. multocida tipo capsular A en una coneja raza cabeza de león (Oryctolagus cuniculus) que únicamente presentaba secreción blanquecina por las fosas nasales. Los signos y lesiones que comúnmente se observan son rinitis, sinusitis, conjuntivitis, dacriocistitis, secreción nasal y ocular. Otros hallazgos no respiratorios son meningitis, dermatitis y piometra que la paciente no presentaba (Rosell & De La Fuente, 2016; Massacci et al., 2018). P. multocida es la bacteria responsable de la pasteurelosis en conejos (Aktories et al., 2012; Wilson & Ho, 2013), a pesar de la diversidad de los signos y lesiones que pueden presentar estos animales se debe sospechar de esta enfermedad aún con escasa signología respiratoria.
La tendencia de utilizar conejos como animales de compañía se ha incrementado, la convivencia con el ser humano es más estrecha comparada con los conejos destinados a la producción; por ende, su estado de salud debe ser supervisado para evitar enfermedades zoonóticas (D’Amico et al., 2022). La pasteurelosis causa una alta morbilidad y mortalidad en conejos sin importar su fin zootécnico, ya sea en producción, como animales de laboratorio o como animales de compañía (Aktories et al., 2012; D’Amico et al., 2022), por lo tanto, la vigilancia de la pasteurelosis en conejos que conviven estrechamente con humanos debe ser monitoreada.
El tipo capsular A es mayormente aislado en casos de pasteurelosis en conejos, y también ha sido reportado como causante de la enfermedad en otras especies animales mamíferos como: cabras, borregos, cerdos y bovinos (Soriano-Vargas et al., 2012). El tipo capsular A también está muy relacionado con el cólera aviar en todo el mundo en diversas especies de aves como pavos, pollos (Harper et al., 2012; Guan et al., 2020), patos (Soriano-Vargas et al., 2012) y otras aves silvestres (Wilson & Ho, 2013).
A nivel internacional existen tendencias para identificar a P. multocida mediante pruebas moleculares como es la PCR, pero la identificación por técnicas estándar fenotípicas es confiable para proporcionar una caracterización definitiva (Dziva et al, 2008). Esta consiste en el aislamiento de la bacteria en AS de carnero al 5 % o en agar infusión cerebro y corazón (AICC), sin desarrollo en agar MacConkey, observación microscópica de bacilos cortos pleomórficos, no flagelados, Gram negativos de tinción bipolar con la tinción de Giemsa, que desarrollan como aerobios facultativos a 37 °C (Dziva et al., 2008; WOAH, 2012; Panna et al., 2015; D’Amico et al., 2022). Las pruebas bioquímicas resultan en catalasa, oxidasa e indol positivas, fermentación de sacarosa, glucosa y maltosa (Dziva et al., 2008; WOAH, 2012; Wilson & Ho, 2013; Panna et al., 2015). Lo anterior asociado a la presentación de la enfermedad en los conejos, es suficiente para caracterizar definitivamente a la bacteria (Dziva et al., 2008), como lo observado en el aislado, donde además se observó la prueba hialuronidasa positiva para identificarla como P. multocida tipo capsular A.
El antibiograma realizado después de la identificación muestra que el aislado de P. multocida es susceptible a cefotaxima, ciprofloxacino, norfloxacina, sulfametoxazoltrimetoprima e imipenem y resistente a neomicina; en la historia clínica se refiere que la paciente fue tratada con enrofloxacina por más de 3 meses sin mejoría alguna. Palócz et al. (2014) reporta que la enrofloxacina es un buen antibiótico contra las infecciones de P. multocida, pero que la vía de administración oral no muestra buen efecto. Bourély et al. (2019) y Jamali et al. (2014) también reportan que las cepas aisladas de cerdos y conejos son sensibles, pero que las aisladas de bovinos y patos, son resistentes. La sensibilidad y resistencia a los antibióticos contra P. multocida es muy variable, esto depende en gran medida de las concentraciones de la bacteria, dosificaciones del antibiótico y especies animales.
Los aislados de P. multocida tipo capsular A de todas las especies son sensibles a una amplia gama de antibióticos como el florfenicol, el trimetoprima-sulfametoxazol y las penicilinas (Gunathilake et al., 2015). Contrario a lo anterior, se reporta que los aislados de bovinos, muestran una marcada resistencia a la penicilina G, estreptomicina, oxitetraciclina, ampicilina y tiamfenicol (Jamali et al., 2014), y son susceptibles a la amoxicilina, amikacina, cefazolina, ceftiofur, cefquinoma, cloranfenicol, enrofloxacina, florfenicol y kanamicina (Jamali et al., 2014; Bourély et al., 2019). Para una mayor eficacia contra P. multocida, los antibióticos de elección deben administrarse combinados. Las mejores combinaciones son con amoxicilina y ácido clavulánico, doxiciclina con metronidazol, clindamicina con ciprofloxacina o combinación de trimetoprimasulfametoxazol o ceftriaxona (Wilson & Ho, 2013). La elección de antibióticos en conejos es limitada, ya que muchos antibióticos orales afectan la microbiota intestinal, provocando infecciones como clostridiasis (Elazab et al., 2018). Ante la variabilidad de susceptibilidad y resistencia mostrada por P. multocida es muy importante que antes de administrar una antibioticoterapia, siempre deben realizarse pruebas de susceptibilidad a antibióticos.
El plasma sanguíneo tiene elementos capaces de proteger al organismo de la presencia de patógenos, entre ellos el sistema complemento, en este estudio se observó el efecto inhibitorio del complemento sérico contra P. multocida. La inhibición del desarrollo de P. multocida en el SN por acción del complemento fue demostrada a diferencia del SIC, donde las proteínas del sistema complemento fueron desnaturalizadas. El sistema complemento es la principal respuesta humoral del sistema inmune innato y tiene gran relevancia en la protección contra las bacterias y otros patógenos invasores debido a su actividad opsónica y citolítica sobre el patógeno, además de su actividad proinflamatoria (Carroll & Isenman, 2012). Aun cuando se demuestra que el sistema complemento tiene acción bactericida contra P. multocida, existen otros componentes en la sangre que tienen acción inhibitoria del desarrollo de la bacteria (Nicholson, 2016). La capacidad del individuo para controlar la infección también depende de otros componentes del sistema inmune como la producción de anticuerpos IgA que inhiben la infección y el desarrollo de la bacteria en la mucosa respiratoria, mientras que, en su invasión a tejidos, depende de la producción de anticuerpos IgG junto con la activación del sistema Complemento (Aktories et al., 2012).
Las cepas encapsuladas de P. multocida serogrupo A de origen aviario son altamente resistentes al complemento y crecen activamente en suero (Harper et al., 2012; Guan et al., 2020). Sin embargo, el aislado de P. multocida obtenido de la coneja fue parcialmente sensible a la acción del complemento tal y como pasa con los mutantes espontáneos con cápsula reducida, o las cepas que han sido tratadas con hialuronidasa, que son generalmente más susceptibles a la aglutinación sérica, destrucción y fagocitosis del suero mediada por el complemento y por los neutrófilos (Guan et al., 2020; Li et al., 2021). Rodentibacter pneumotropicus (antes Pasteurella pneumotropica) sobrevive en un 50% cuando se incuba con SN, por lo que R. pneumotropicus ha desarrollado mecanismos para evadir el sistema complemento humano que pueden aumentar la eficiencia para acceder y colonizar los tejidos internos donde puede causar infecciones graves (Sahagun-Ruiz et al., 2014).
Las infecciones por P. multocida en humanos surgen como resultado de heridas donde las mordeduras o arañazos de conejos están implicados evidenciando la antropozoonosis (Lin et al., 2006; Per et al., 2010; D’Amico et al., 2022). Cuando estas infecciones no son consecuencia de heridas por mordedura, suelen estar relacionadas con el contacto de las lesiones cutáneas, naso-orofaringeas o de mucosas respiratorias superiores, especialmente en niños pequeños, ancianos, personas embarazadas o inmunodeprimidas (Baud et al., 2012; Wilson & Ho, 2013, D'Amico et al, 2022). Los conejos utilizados para uso doméstico que son portadores de P. multocida son una potencial fuente de infección para humanos expuestos a los conejos infectados, como: médicos veterinarios, dueños, criadores, personal de rastros que están en contacto con ellos.
CONCLUSIONES
Existe una reducción en el número de UFCs de P. multocida al exponerlas al complemento activo presente en el suero humano normal en comparación con las expuestas al suero inactivado. El complemento humano es un componente del sistema inmune que ofrece resistencia parcial al desarrollo de P. multocida tipo capsular A.










text in 



